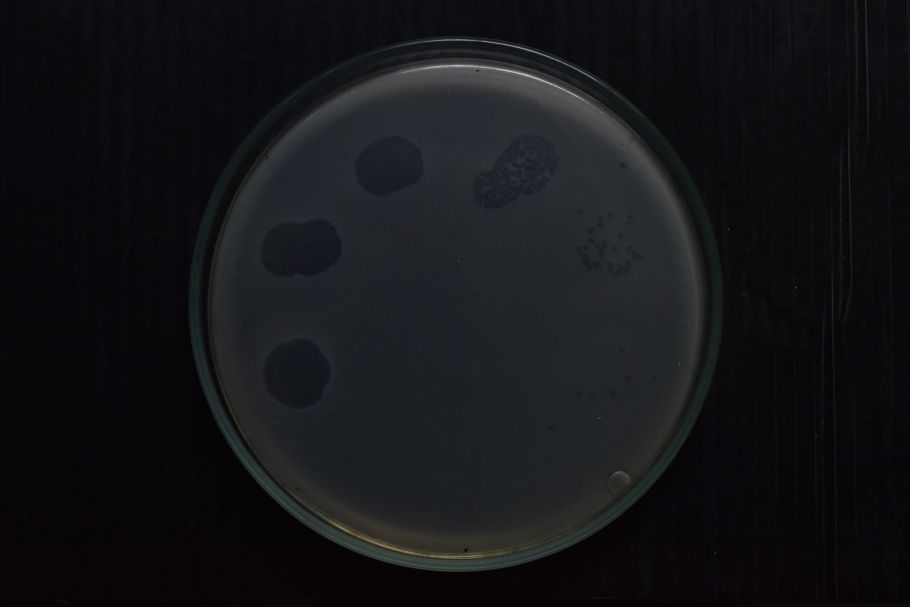

Acerca de nosotros

Visión:
En el CIMIC buscamos construir una sociedad más sostenible, a través de la formación de capital humano, el avance científico en microbiología ambiental e industrial y el desarrollo tecnológico, aplicando los más altos estándares éticos y utilizando tecnologías y metodologías de vanguardia a nivel internacional. Nuestro compromiso es el desarrollo de soluciones biotecnológicas que den respuesta a los retos más importantes del país, preservando su biodiversidad y formando profesionales expertos en el campo.

Misión:
Teniendo en cuenta la trayectoria del grupo en materia de formación, generación de nuevo conocimiento e impacto a la sociedad, en los próximos 10 años queremos ser reconocidos por nuestras soluciones innovadoras a los desafíos más importantes y su transferencia a diversos sectores, promoviendo la innovación y el emprendimiento para la creación de valor económico, social y ambiental, y contribuyendo al desarrollo sostenible de Colombia y la región.
Nuestra Investigación
Biorremediación y sostenibilidad ambiental
A partir del conocimiento ómico (genómico, transcriptómico y proteómico) de microorganismos con potencial de biotransformación de contaminantes en agua, suelo y aire, trabajamos en su aplicación y potencialización metabólica para la descontaminación ambiental y la mitigación del cambio climático
Innovación y sostenibilidad industrial
El estudio de microorganismos, sus interacciones entre sí y con su entorno, así como sus componentes celulares y moleculares, permiten diseñar e innovar con estrategias sostenibles para la obtención de bioproductos y/o bioinsumos, el mejoramiento de bioprocesos, y el aprovechamiento de residuos orgánicos.
Bioprospección y conservación de la biodiversidad
Empleamos tecnología de punta para la bioprospección de bacteriófagos y microorganismos como estrategia fundamental en el estudio sistemático de la biodiversidad, desde sus componentes moleculares hasta organismos completos, con la perspectiva de conservación y utilización en la solución de problemas.
Directores del Laboratorio

María Francisca Villegas
Profesora Asistente Departamento de Ciencias Biológicas
Esta dirección de correo electrónico está siendo protegida contra los robots de spam. Necesita tener JavaScript habilitado para poder verlo.

Josman Andrey Velasco Mendoza
Profesor Asistente Departamento de Ciencias Biológicas
Esta dirección de correo electrónico está siendo protegida contra los robots de spam. Necesita tener JavaScript habilitado para poder verlo.

Martha Josefina Vives
Profesora Titular Departamento de Ciencias Biológicas
Esta dirección de correo electrónico está siendo protegida contra los robots de spam. Necesita tener JavaScript habilitado para poder verlo.
Edificio J - Piso 2 - 3
Teléfono: (+57) 601 3 39 4999 Ext 2767 | 1461
Carrera 1 No.18A - 12
Bogotá, Colombia